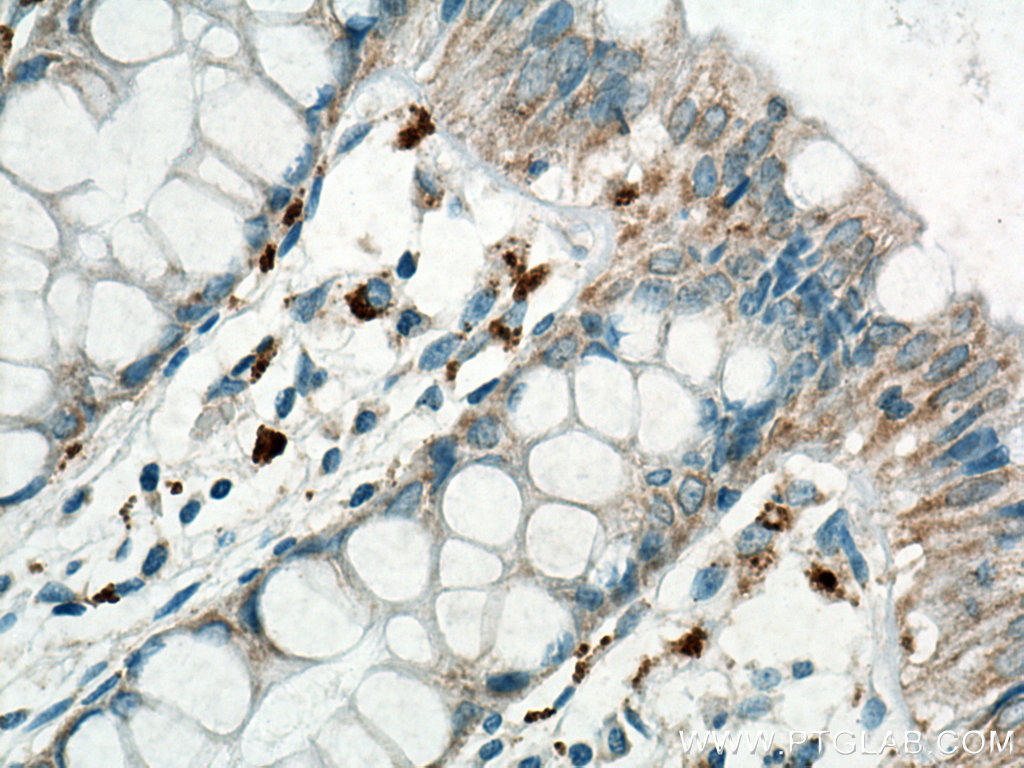

MICA/MICB 抗体(anti MICA/MICB antibody)は、ヒト MICA/MICB 細胞表面マーカータンパク質を検出するモノクローナル抗体(クローン番号:6D4)です。フローサイトメトリー(FC)、ELISA実験に使用できます。
[便利なバッファーキット]細胞内フローサイトメトリー解析用バッファーキット
[FC実験の必需品]アイソタイプコントロール
MICA/MICB 抗体(anti MICA/MICB antibody)は、ヒト MICA/MICB 細胞表面マーカータンパク質を検出するモノクローナル抗体(クローン番号:6D4)です。フローサイトメトリー(FC)、ELISA実験に使用できます。
[便利なバッファーキット]細胞内フローサイトメトリー解析用バッファーキット
[FC実験の必需品]アイソタイプコントロール
Proteintech Group, Inc.(プロテインテック)社は、2001年に設立された抗体製造メーカーです。現在までに、米国本社の他、英国、中国、ドイツ、フランス、シンガポール等で支社を展開し、各国で様々なマーカー抗体、タンパク質研究用試薬を供給しています。国内におけるテクニカルサポート等は、2016年より株式会社プロテインテック・ジャパン(www.ptglab.co.jp
)が担当しています。
プロテインテックは、引用数ランキング付き抗体検索サイトを運営する英国の「CiteAb
」が主催する「2025 CiteAb Awards」において「Researchers' choice(研究者の選択)
」部門および「Educational Resource of the Year(今年の教育リソース)
」部門の受賞者として選出されました。優れた品質と製品ラインアップに加え、カスタマーサービスや教育コンテンツが高く評価されています。
以下のリンクから、プロテインテックの主なカテゴリー製品をご覧いただけます。
| 商品名 | MICA/MICB 抗体(Anti MICA/MICB antibody [Clone: 6D4 |
|---|---|
| 品番 | 65161-1-Ig |
| タイプ | モノクローナル |
| 交差種 | ヒト |
| アプリケーション | FC(フローサイトメトリー)、ELISA |
| 標識 | 非標識、FITC、PE、APC、Biotin |
| クローン番号 (Clone number) | クローン:6D4
|
| 免疫原由来動物種 | ヒト(human) |
| 免疫原 | Transfected C1R cells expressing MICA |
| 宿主動物/免疫動物 | マウス(Mouse) |
| アイソタイプ | Mouse IgG2a (クリックでアイソタイプコントロールや二次抗体を検索できます。) |
| 別名 | MHC class I polypeptide-related sequence A, MICA, MICB |
| GeneID (遺伝子データベース情報) | 4276 |
| バッファー | PBS with 0.1% sodium azide. |
| 精製方法 | Purified by protein-A affinity chromatography |
| 保存方法 | Store at 2-8℃. |
プロテインテックのフローサイトメトリー用抗体は、FITC、PE、APC、およびプロテインテック独自の色素であるCoraLite®(コーラライト)を含む様々なフルオロフォアに結合しています。各種CoraLite®(コーラライト)色素は、一般的に広く用いられているAlexa Fluor®蛍光色素と同等の明るさを持ち、長期的な蛍光を提供します。CoraLite®(コーラライト)色素は、重複する蛍光スペクトルが最小限であるため、他の一般的な色素と容易に多重化できます。
プロテインテックの蛍光スペクトルビューアーは、Fluorofinder
のプラットフォームを搭載しており、フローサイトメトリー実験のデザインに便利です。
フローサイトメトリーのスタンダードプロトコールは以下のリンク先PDF資料を参照ください。
プロテインテックでは、フローサイトメトリー実験に最適な各種バッファーを販売しています。全血サンプルをはじめとする赤血球を含むサンプルの調製には赤血球溶解バッファーをご検討ください。細胞表面マーカーと細胞内タンパク質の同時染色を実施する際には固定・透過処理バッファーセットである細胞内フローサイトメトリー解析試薬をご検討ください。

■ 非標識モノクローナル抗体
| 品名 | メーカー | 品番 | 包装 | 希望販売価格 |
|---|---|---|---|---|
Anti MICA/MICB, Human (Mouse) Unlabeled, 6D4![]() |
PGI | 65161-1-IG | 100 UG |
お問い合わせ |
■ FITC標識モノクローナル抗体
| 品名 | メーカー | 品番 | 包装 | 希望販売価格 |
|---|---|---|---|---|
Anti MICA/MICB, Human (Mouse) Fluorescein Isothiocyanate, 6D4![]() |
PGI | FITC-65161 | 100 TEST |
¥33,000 |
■ PE標識モノクローナル抗体
| 品名 | メーカー | 品番 | 包装 | 希望販売価格 |
|---|---|---|---|---|
Anti MICA/MICB, Human (Mouse) Phycoerythrin, 6D4![]() |
PGI | PE-65161 | 100 TEST |
お問い合わせ |
■ APC標識モノクローナル抗体
| 品名 | メーカー | 品番 | 包装 | 希望販売価格 |
|---|---|---|---|---|
Anti MICA/MICB, Human (Mouse) Allophycocyanin, 6D4![]() |
PGI | APC-65161 | 100 TEST |
¥39,000 |
■ Biotin標識モノクローナル抗体
| 品名 | メーカー | 品番 | 包装 | 希望販売価格 |
|---|---|---|---|---|
Anti MICA/MICB, Human (Mouse) Biotin, 6D4![]() |
PGI | BIOTIN-65161 | 100 UG |
¥26,000 |
商品は「研究用試薬」です。人や動物の医療用・臨床診断用・食品用としては使用しないように、十分ご注意ください。
※ 表示価格について
© COSMO BIO